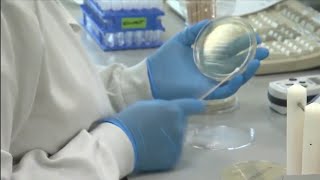

Washington labs work to identify COVID 19 variants as cases climb video
Online izle ve mp4 mp3 formatlarinda yukle

Videonun muddeti: 1:38
Washington labs work to identify COVID 19 variants as cases climb videosu mp4 ve mp3 yuklemek ucun hazirdir
Diqqet! Siz Mp4 yukle ve ya Mp3 yukle duymesine basdiqdan sonra eger sistem sizi reklam sehifesine atarsa o zaman derhal geri qayidib emeliyyati tekrar edin ve faylin yuklemek ucun hazir olmasini gozleyin
Videodan Mp4 Yukle
Videodan Mp3 Yukle-1
Videodan Mp3 Yukle-2
Oxshar Axtarishlar
 Washington labs work to identify COVID-19 variants as cases climb
Washington labs work to identify COVID-19 variants as cases climb Inside A U.S. Lab Working To Identify, Isolate Coronavirus Variants | NBC News NOW
Inside A U.S. Lab Working To Identify, Isolate Coronavirus Variants | NBC News NOW State labs work to identify more cases of COVID-19 variant
State labs work to identify more cases of COVID-19 variant What we know about the latest coronavirus variants
What we know about the latest coronavirus variants Inside A U.S. Lab Working To Identify, Isolate Coronavirus Variants | NBC News NOW
Inside A U.S. Lab Working To Identify, Isolate Coronavirus Variants | NBC News NOW Pandemic Stories: An inside look at the DOH Public Health Lab as scientists track COVID variants
Pandemic Stories: An inside look at the DOH Public Health Lab as scientists track COVID variants Metro Health working to identify if new coronavirus variant has made its way to Bexar County
Metro Health working to identify if new coronavirus variant has made its way to Bexar County WHO's Science in 5: COVID-19 evolving variants and how to stay safe - 04 May 2023 - SHORT
WHO's Science in 5: COVID-19 evolving variants and how to stay safe - 04 May 2023 - SHORT Officials working to better detect COVID variants
Officials working to better detect COVID variants
Video Mp4 Mp3Azwap.Biz
Azwap.Biz 2021-2023


 Washington labs work to identify COVID-19 variants as cases climb
Washington labs work to identify COVID-19 variants as cases climb Inside A U.S. Lab Working To Identify, Isolate Coronavirus Variants | NBC News NOW
Inside A U.S. Lab Working To Identify, Isolate Coronavirus Variants | NBC News NOW State labs work to identify more cases of COVID-19 variant
State labs work to identify more cases of COVID-19 variant What we know about the latest coronavirus variants
What we know about the latest coronavirus variants Inside A U.S. Lab Working To Identify, Isolate Coronavirus Variants | NBC News NOW
Inside A U.S. Lab Working To Identify, Isolate Coronavirus Variants | NBC News NOW Pandemic Stories: An inside look at the DOH Public Health Lab as scientists track COVID variants
Pandemic Stories: An inside look at the DOH Public Health Lab as scientists track COVID variants Metro Health working to identify if new coronavirus variant has made its way to Bexar County
Metro Health working to identify if new coronavirus variant has made its way to Bexar County WHO's Science in 5: COVID-19 evolving variants and how to stay safe - 04 May 2023 - SHORT
WHO's Science in 5: COVID-19 evolving variants and how to stay safe - 04 May 2023 - SHORT Officials working to better detect COVID variants
Officials working to better detect COVID variants